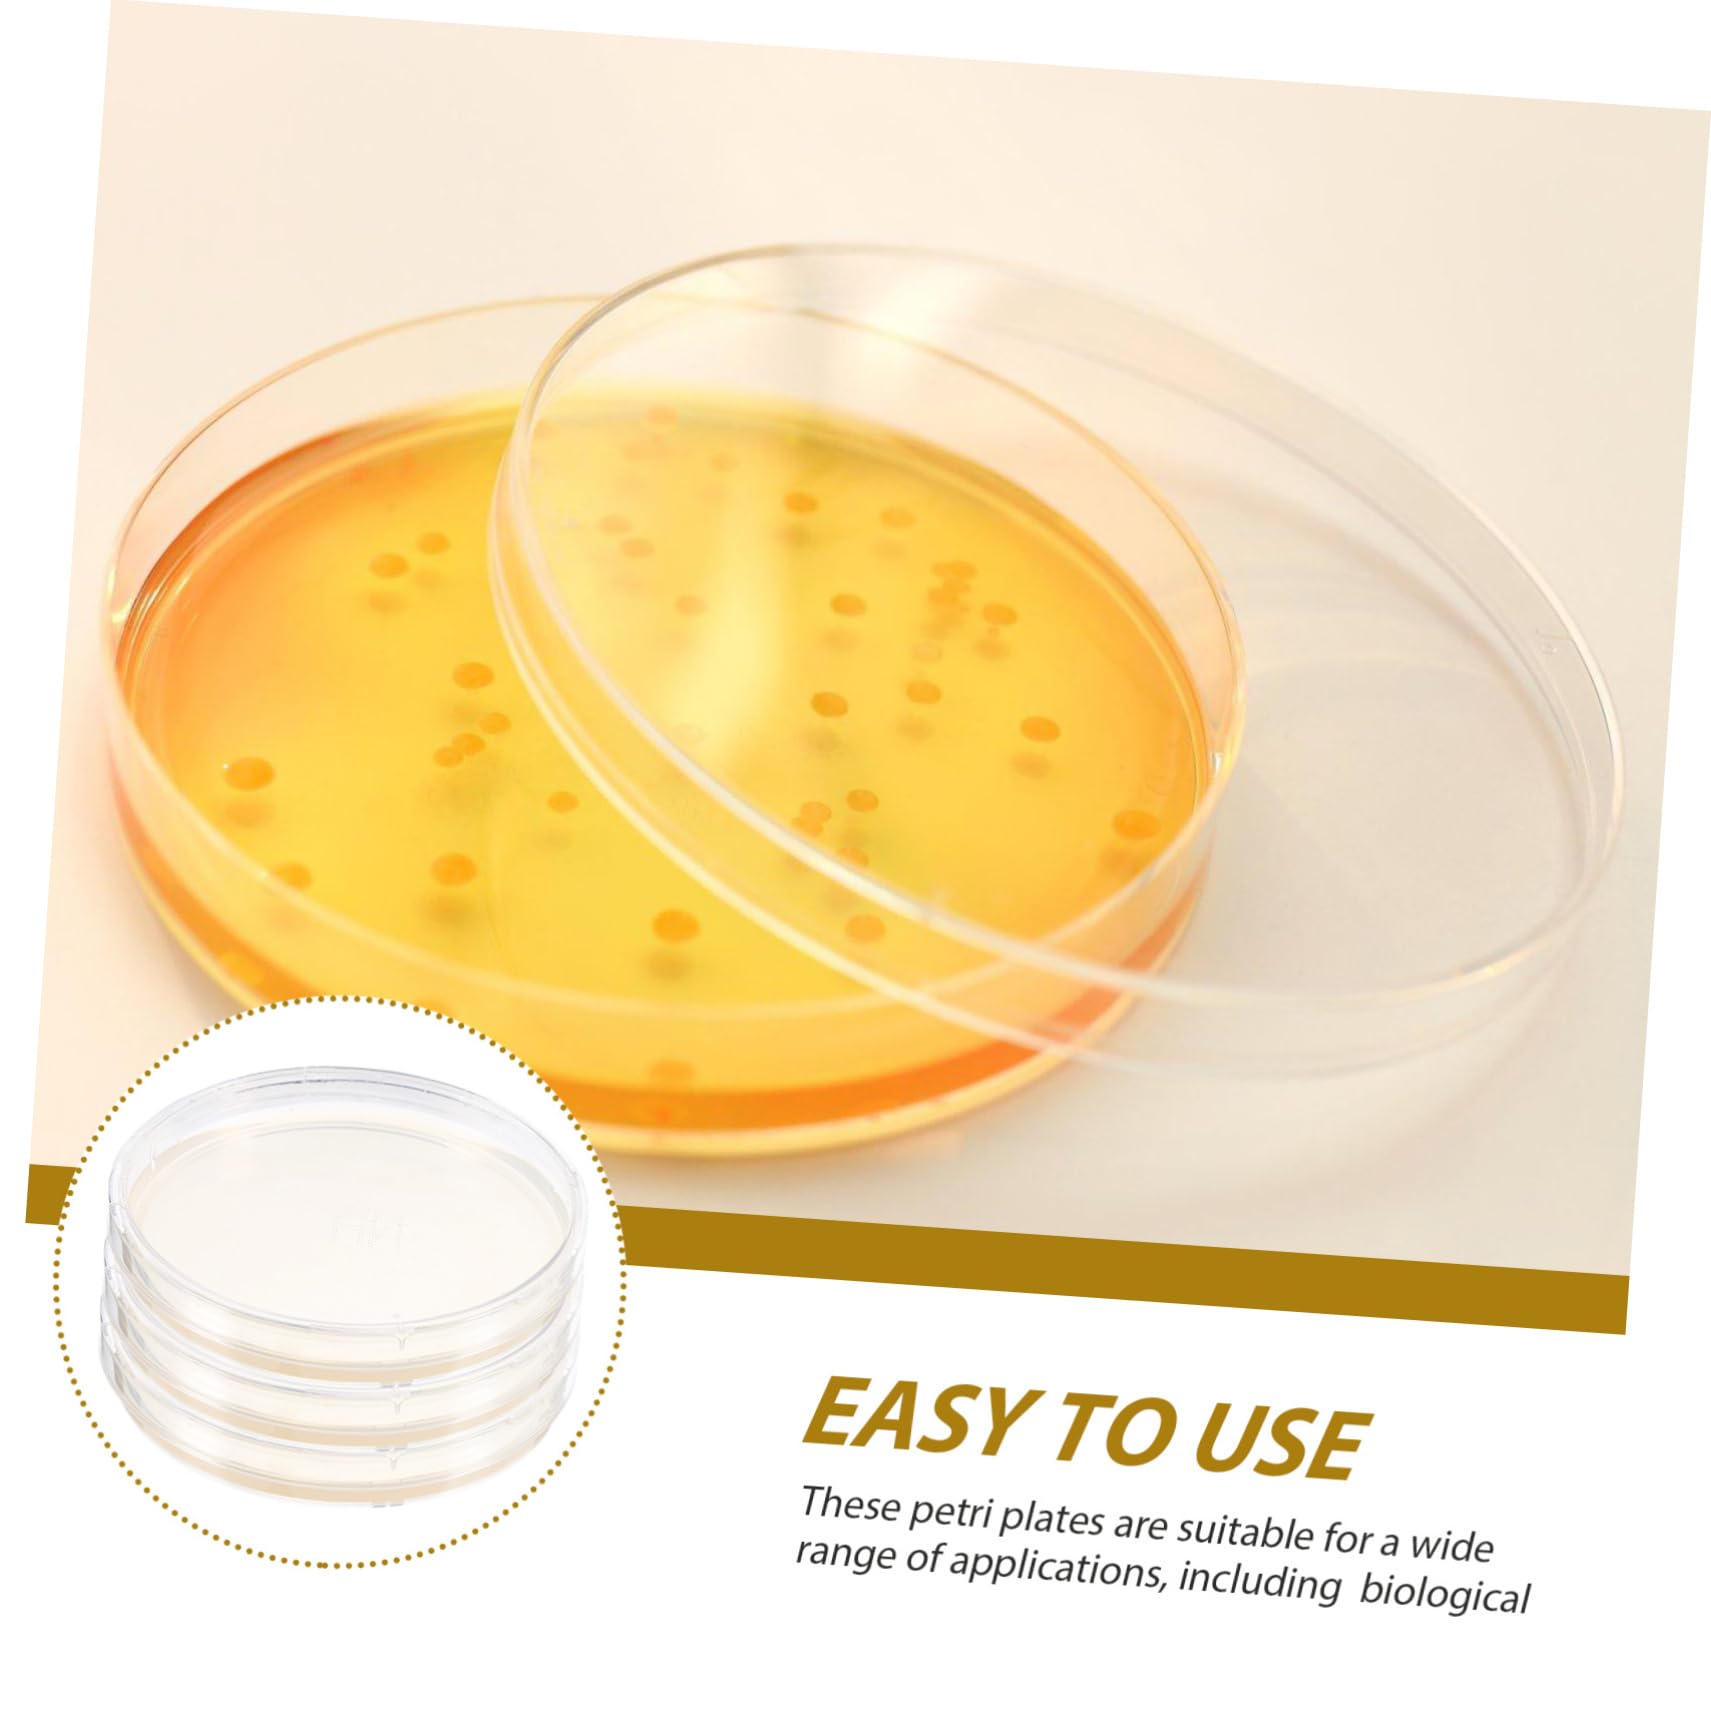
BUGUUYO 10pcs Agar Plate Petri Dishes Science Experiment Supplies Prepoured Petri Dish Agar Petri Plates Laboratory Supplies Science Experiment Plates Science Projects Tool

Product Information
Specification
Brand : BUGUUYO
BulletPoint1 : Science projects tool-- these agar plates are ideal for young students learning science, technology, engineering, and mathematics.
BulletPoint2 : Agar plates for laboratory-- these agar plates are good workmanship that are designed to withstand long-term use, ensuring that they won't deform or break easily.
BulletPoint3 : Laboratory supplies-- our agar plates are highly practical and easy to use, providing a great user experience for anyone conducting science experiments.
BulletPoint4 : Petri dishes-- our agar plates are crafted with exquisite workmanship and are perfect for science experiments of all kinds.
BulletPoint5 : Prepoured petri dish-- these petri plates are suitable for a wide range of , including medical, , scientific research, and laboratory analysis.
Color : As Shown
ExternallyAssignedProductIdentifier : 3403484152604
FabricType : ABS
FdaDeviceClassification : ii
FdaIndicationOfUse : rx
FdaInstructionsForUseType : na
FdaLabelType : consumer
FdaPremarketApprovalNumber510k : 1
FdaPremarketApprovalNumberPma : 1
IncludedComponents : storage holder
IsDishwasherSafe : 1
ItemDisplayDimensions_Length : 3.54 centimeters
ItemDisplayDimensions_Width : 6.3 centimeters
ItemName : BUGUUYO 10pcs Agar Plate Petri Dishes Science Experiment Supplies Prepoured Petri Dish Agar Petri Plates Laboratory Supplies Science Experiment Plates Science Projects Tool
ItemPackageDimensions_Height : 3.54 inches
ItemPackageDimensions_Length : 5.71 inches
ItemPackageDimensions_Width : 3.54 inches
ItemPackageQuantity : 3
ItemTypeKeyword : science-lab-petri-dishes
ItemVolume : 1 cubic_centimeters
Manufacturer : BUGUUYO
Material : agar
ModelName : M2
ModelNumber : CO220650XGSR
NumberOfItems : 1
NumberOfLithiumMetalCells : 1
PartNumber : CO220650XGSR
ProductDescription : Package List
10 x Agar Plates
Characteristics
-Material:Agar prepoured petri plates
-Size:9.00X9.00X2.00cm/3.54X3.54X0 portable agar
-Color:As Shown petri dishes with agar
-Our agar plates facilitate proper agar consistency and thickness, eliminating the need for technical agar melting and pouring portable agar plates.
-Compact and lightweight design of these petri plates makes them easy to use and transport, convenient tool for any science experiment laboratory experiment supplies.
-Our agar plates are crafted with exquisite workmanship and are perfect for science experiments of all kinds experiment supplies.
-Our agar plates are a necessary accessory for any science experiment, providing a better user experience science experiment supplies.
-These agar plates are ideal for young students learning science, technology, engineering, and mathematics agar plates for laboratory.
Goods Description
agar plate They are designed to satisfy your needs and provide you with a reliable solution for your science experiments.petri dish If you're looking for practical agar plates, our products are the perfect choice.laboratory experiment supplies With their sturdy construction and excellent craftsmanship, these agar plates are easy to use and transport, good for many uses
ProductSiteLaunchDate : 2024-06-22T13:03:39.344Z
Size : 9.00X9.00X2.00CM
Style : Kidney Shape
SupplierDeclaredDgHzRegulation : not_applicable
UnitCount : 1